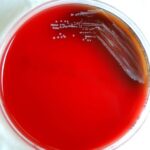

Author Archives 
Dr. Rae Osborn was educated in South Africa and the United States. She holds Honors Bachelor of Science degrees in Zoology and Entomology, and Masters of Science in Entomology from the University of Natal in South Africa. She has received a PhD in Quantitative Biology from the University of Texas at Arlington as well as an AAS Degree in Information Network Specialist and an AAS in Computer Information Systems, at Bossier Parish Community College in Louisiana. Her skills lie in research and writing for a range of educational levels and teaching various Biology classes. She has been trained as a lecturer, researcher and computer scientist. She has experience as a writer, researcher and as a college teacher, and is currently working as a freelance writer and editor. Her accomplishments include receiving tenure and being promoted to Associate Professor of Biology in the United States and publishing papers in peer-reviewed journals. Her hometown is Pietermaritzburg in South Africa where her main interest and hobby is bird watching.
-

Difference Between Rumination and Regurgitation
-

Difference Between Pyelectasis and Hydronephrosis
-

Difference Between Cellulitis and Erysipelas
-

Difference Between PTSD and ASD
-

Difference Between Constipation and Bowel Obstruction
-

Difference Between Constipation and Diarrhea
-

Difference Between Cellulite and Stretch Marks
-

Difference Between Epidemic and Pandemic
-

Difference Between UTI and Yeast Infection
-

Difference Between Unsaturated and Saturated Fats
-

Difference Between Acetaminophen and Ibuprofen
-

Difference Between Doula and Midwife
-

Difference Between Dandruff and Dry Scalp
-

Difference Between AIDS and HIV
-

Difference Between Stomach Flu and Food Poisoning
-

Difference Between Oxycontin and Oxycodone
-

Difference Between Dietitian and Nutritionist
-

Difference Between Cold and Sinus Infection
-

Difference Between Aerobic and Anaerobic Exercise
-

Difference Between Rheumatoid Arthritis and Osteoarthritis
-

Difference Between Good and Bad Cholesterol
-

Difference Between Caesarian Section and Normal Birth
-

Difference Between Somatic and Psychosomatic
-

Difference Between Male and Female Dogs
-

Difference Between Sweet Potatoes and Yams
-

Difference Between Dog and Cat Food
-

Difference Between Sore Throat and Strep Throat
-

Difference Between Ethnicity and Race
-

Difference Between a Psychologist and a Psychiatrist
-

Difference Between Sacroiliitis and Sciatica
-

Difference Between Hordeolum and Chalazion and Blepharitis
-

Difference Between Somatic Hypermutation and Class Switching
-

Difference Between Somatic Hypermutation and Affinity Maturation
-

Difference Between Trismus and Lockjaw
-

Difference Between Pericoronitis and Periodontitis
-

Difference Between Panhypopituitarism and Hypopituitarism
-

Difference Between Niemann Pick Disease and Tay Sachs
-

Difference Between Hyposmia and Anosmia
-

Difference Between Hypopituitarism and Hyperpituitarism
-

Difference Between Gonorrhea and Trichomoniasis
-

Difference Between Candidiasis and Gonorrhea
-

Difference Between Vesicles and Papules
-

Difference Between Floaters and Flashes
-

Difference Between Bullous Impetigo and Bullous Pemphigoid
-

Difference Between Cumulus and Stratus Clouds
-

Difference Between Threading and Tweezing
-

Difference Between Immediate and Delayed Hypersensitivity
-

Difference Between Hair Mousse and Hair Spray
-

Difference Between Diurnal Rhythm and Circadian
-

Difference Between Blepharitis and Preseptal Cellulitis
-

Difference Between Vesicular and Pustular
-

Difference Between Acute and Chronic Insomnia
-

Difference Between Vesicular and Bronchial Breath Sounds
-

Difference Between Werner Syndrome and Progeria
-

Difference Between Pustules and Cysts
-

Difference Between Liver Fibrosis and Cirrhosis
-

Difference Between Liver and Kidney Function
-

Difference Between Raynaud’s Syndrome and Disease
-

Difference Between Bell’s Palsy and Lyme Disease
-

Difference Between Palpitations and Arrhythmia
-

Difference Between Somatization and Hypochondriasis
-

Difference Between Rectocele and Rectal Prolapse
-

Difference Between Arnold-Chiari Malformation Type 1 and Type 2
-

Difference Between Somatic and Visceral
-

Difference Between Ramsay Hunt Syndrome and Bell’s Palsy
-

Difference Between Bullous Pemphigoid and Pemphigus Vulgaris
-

Difference Between a Lupus Rash and Rosacea
-

Difference Between Bell’s Palsy and Stroke
-

Difference Between Paget’s Disease and Osteosarcoma
-

Difference Between Pulmonary Embolism and Deep Vein Thrombosis
-

Difference Between Chronic Lymphocytic Leukemia and Acute Lymphoblastic Leukemia
-

Difference Between Gastroesophageal Reflux Disease (GERD) and Peptic Ulcer Disease
-

Difference Between Mesothelioma and Lung Cancer
-

Difference Between Eco Friendly and Sustainable
-
Difference Between Typhoid and Yellow Fever
-

Difference Between TB Ulcer and Typhoid Ulcer
-

Difference Between Osteoporosis and Osteomyelitis
-

Difference Between Osteomyelitis and Osteomalacia
-

Difference Between Cholera and Typhoid
-

Difference Between Granulomatous and Non-Granulomatous
-

Difference Between Typhoid Vaccine Oral and Injection
-

Difference Between Hydromulch and Hydroseed
-

Difference Between Tonic and Phasic Receptors
-

Difference Between Hematoma and Hemorrhage
-

Difference Between Fetal Alcohol Syndrome and Down Syndrome
-

Difference Between Healing and Infected Belly Button Piercing
-

Difference Between Gum and Mucilage
-

Difference Between Fasciculations and Myokymia
-

Difference Between Retractile Testis and Undescended Testis
-

Difference Between Hematoma and Hemangioma
-

Difference Between Bruise and Purpura
-

Difference Between Granuloma Annulare and Tinea Corporis
-

Difference Between Enteric Fever and Typhoid Fever
-

Difference Between Hematoma and Pseudoaneurysm
-

Difference Between Ulcerative Colitis and Diverticulitis
-

Difference Between Hemorrhage and Aneurysm
-

Difference Between Granuloma and Keloid
-

Difference Between Acute Subdural Hematoma and Chronic
-

Difference Between Typhoid and Typhus
-

Difference Between Perianal Hematoma and Hemorrhoids
-

Difference Between Hematoma and Blood Clot
-

Difference Between Umbilical Granuloma and Polyp
-

Difference Between Subdural Hematoma and Subarachnoid Hemorrhage
-

Difference Between Subchorionic Hematoma Bleeding and Miscarriage
-

Difference Between Subgaleal Hematoma and Cephalohematoma
-

Difference Between Cytokine Release Syndrome and Cytokine Storm
-

Difference Between Cytokinesis and Karyokinesis
-

Difference Between Cure and Treatment
-

Difference Between Toenail Hematoma and Melanoma
-

Difference Between Thyrotoxicosis and Thyroid Storm
-

Difference Between Malaria and Typhoid Symptoms
-

Difference Between Healing Bump and Keloid
-

Difference Between Trichomonas and Giardia
-

Difference Between Giardiasis and Amebiasis
-

Difference Between Diphtheria and Tonsillitis
-

Difference Between Diphtheria and Strep Throat
-

Difference Between Muscovite and Mica
-

Difference Between Actinic Keratosis and Solar Keratosis
-

Difference Between Cocktail Party Effect and Selective Attention
-

Difference Between Aversion Therapy and Flooding
-

Difference Between Akinesia and Apraxia
-

Difference Between Ileorectal Anastomosis and J-Pouch
-

Difference Between Ecchymosis and Petechiae
-

Difference Between Thrombolytic and Antiplatelet
-

Difference Between Anticoagulants and Fibrinolytics
-

Difference Between Bruising and Internal Bleeding
-

Difference Between Authoritarian and Libertarian
-

Difference Between Aortic Ectasia and Aneurysm
-

Difference Between Hematochezia and Melena
-

Difference Between Hamartoma and Teratoma
-

Difference Between Ecchymosis and Contusion
-

Difference Between Content and Context in Education
-

Difference Between Bruising and Hematoma
-

Difference Between Hamartoma and Choristoma
-

Difference Between Cataplexy and Catalepsy
-

Difference Between Bruxism and Sleep Apnea
-

Difference Between Ecchymosis and Hematoma
-

Difference Between Spirometry and Pulmonary Function Test
-

Difference Between Cochlear Implant and Hearing Aid
-

Difference Between Spirometry for Asthma and Spirometry COPD
-

Difference Between Supernatant and Precipitate
-

Difference Between Neuromodulation and Neurostimulation
-

Difference Between Achalasia and Scleroderma
-

Difference Between Bacteria and Mollicutes
-

Difference Between Bronchitis and Sinus Infection
-

Difference Between Tension Headache and Meningitis
-

Difference Between Epidural and Natural Birth
-

Difference Between Norovirus and Norwalk
-

Difference Between Pleurodesis and Decortication
-

Difference Between Irritable Bowel Syndrome and Lactose Intolerance
-

Difference Between Achalasia and Esophageal stricture
-

Difference Between Achalasia and Dysphagia
-

Difference Between Omega-3 and Vitamin D
-

Difference Between Vitamin B6 and Vitamin B12
-

Difference Between Pericarditis and Endocarditis
-

Difference Between Pericarditis and Myocarditis
-

Difference Between Pericarditis and Cardiac Tamponade
-

Difference Between Adnexal Cyst and Ovarian Cyst
-

Difference Between Adenoma and Hyperplastic Polyp
-

Difference Between Immunosuppression and Immunodeficiency
-

Difference Between Bone Scan and Bone Density Scan
-

Difference Between Impetigo and Ringworm
-

Difference Between Sarcoidosis and Lymphoma
-

Difference Between Apocrine and Merocrine Sweat Glands
-

Difference Between Amyloidosis and Sarcoidosis
-

Difference Between Akinesia and Akathisia
-

Difference Between Tennis Elbow and Golfer’s Elbow
-

Difference Between Angiogenesis and Vasculogenesis
-

Difference Between Covid Toes and Gout
-
Difference Between Bacteremia and Sepsis
-

Difference Between Ascites and Belly Fat
-

Difference Between Super Spreader and Silent Spreader
-

Difference Between Covid Toes and Athlete’s Foot
-

Difference Between Metals, Metalloids, and Nonmetals
-

Difference Between Alpha, Beta, Gamma, and Delta Variants in Coronavirus
-

Difference Between Hernia and Ulcer
-

Difference Between ARFID and OCD
-

Difference Between Covid and Long Covid or Post Covid
-

Difference Between Gallstones and Kidney Stones Pain
-

Difference Between Remdesivir and Dexamethasone
-

Difference Between Gallstones and Appendicitis
-

Difference Between Medical and Surgical Asepsis
-

Difference Between Heart Attack and Heart Failure
-

Difference Between Carbs and Net Carbs
-

Difference Between Remdesivir and Regeneron
-

Difference Between ARFID and Autism
-

Difference Between Constipation and Gas
-

Difference Between Gallstones and Pancreatitis
-

Difference Between Blood and Plasma Donation
-

Difference Between Actinic Keratosis and Melanoma
-

Difference Between Blood Groups A, B, AB, and O
-

Difference Between Actinic Keratosis and Psoriasis
-

Difference Between Actinic Keratosis and Squamous Cell Carcinoma
-

Difference Between Albumin and Microalbumin
-

Difference Between Absence Seizures and Dissociation
-

Difference Between Primary and Secondary Assessment
-

Difference Between Peptide Vaccine and mRNA Vaccine
-

Difference Between Sinovac Vaccine and Pfizer
-

Difference Between Surgery and Radiation for Prostate Cancer
-

Difference Between Convalescent Plasma Therapy and Monoclonal Antibodies
-

Difference Between Variant Covid-19 and Covid-19
-

Difference Between Covid-19 and Allergies
-

Difference Between Metamucil and Miralax
-

Difference Between Coronaviruses – Alpha, Beta, Gamma, and Delta
-

Difference Between Cellular Immunity and Herd Immunity
-

Difference Between Herd Immunity and Natural Immunity
-

Difference Between Viral Shedding and Viral Load
-

Difference Between Infectious and Chronic Disease
-

Difference Between mRNA Vaccine and Traditional Vaccine
-

Difference Between Antibody Test and Swab Test
-

Difference Between Adjuvant and Neoadjuvant Therapy
-

Difference Between RNA and DNA vaccines
-

Difference Between Psychodynamic Therapy and CBT
-

Difference Between Communicable and Noncommunicable Disease
-

Difference Between Pulmonary Infiltrate and Effusion
-

Difference Between Herd Immunity and Ring Immunity
-

Difference Between Hemoptysis and Dyspnea
-

Difference Between Epistaxis and Hemoptysis
-

Difference Between Incubation Period and Infectious Period
-

Difference Between Cough Suppressant and Expectorant
-

Difference Between Antitussive and Expectorant
-

Difference Between Coronavirus and Tuberculosis
-

Difference Between Adapalene and Retinol
-

Difference Between Pheochromocytoma and Neuroblastoma
-

Difference Between Hemoptysis and Hematemesis
-

Difference Between Ageusia and Anosmia
-

Difference Between Health Promotion and Health Education
-

Difference Between Threshold and Tolerance
-

Difference Between T Cells and Antibodies
-

Difference Between Amygdala and Hippocampus
-

Difference Between Aberration and Extinction
-

Difference Between Oligotrophic and Eutrophic
-

Difference Between Pandemic and Epidemic and Plague
-

Difference Between Quarantine and Isolation
-

Difference Between Outbreak and Pandemic
-

Difference Between Headache and Aneurysm
-

Difference Between Follicular Adenoma and Carcinoma
-

Difference Between Meniere’s Disease and Labyrinthitis
-

Difference Between Bottleneck Effect and Founder Effect
-

Difference Between Mastoiditis and Otitis Media
-

Difference Between Dementia and Mild Cognitive Impairment
-

Difference Between Tension Headache and Cluster Headache
-

Difference Between Non-Medical Masks and Medical
-

Difference Between Dementia and Senility
-

Difference Between Migraine and Cervicogenic Headache
-

Difference Between Migraine and Cluster Headache
-

Difference Between Lymphatic Capillaries and Blood Capillaries
-

Difference Between Coronavirus and Spanish Flu
-

Difference Between Coronavirus vs Flu vs Cold vs Allergies
-

Difference Between Thin and Thick Skin
-

Difference Between Seizure and Passing out
-

Difference Between Covid-19 and Coronavirus
-

Difference Between Coronavirus and RSV
-

Difference Between Bronchitis and Pleurisy
-

Difference Between Coronavirus and H1N1
-

Difference Between Parasite and Parasitoid
-

Difference Between Coronavirus and Ebola
-

Difference Between Coronavirus and Cold Symptoms
-

Difference Between Differin and Retin-A
-

Difference Between Breastfeeding and Formula
-

Difference between Coronavirus and SARS
-

Difference Between Thyroid and Thymus
-

Difference Between Homozygous and Heterozygous
-

Difference Between Homologous and Analogous Structures
-

Difference Between a Donkey and a Burro
-

Difference Between Keto Diet and Diabetes Diet
-
Difference between Asthma and Croup
-

Difference Between Figs and Dates
-

Difference Between Asthma and Reactive Airway Disease
-

Difference Between Acetone and Acetic Acid
-

Difference Between Fast Metabolism and Slow Metabolism
-

Difference Between Cannabis and Alcohol
-

Difference Between Classic and Mosaic Turner Syndrome
-

Difference Between Gestational Diabetes and Type 2 Diabetes
-

Difference Between Collagen and Elastin
-

Difference Between Torque and Force
-

Difference Between Adjustment Disorder and Anxiety
-

Difference Between Thyroid and Goiter
-

Difference Between Fistula and Fissure
-

Difference Between Collagen and Retinol
-

Difference Between Adjustment Disorder and MDD
-

Difference Between Menopause and Postmenopause
-

Difference Between Staging and Grading
-

Difference Between Bronchitis and Bronchiectasis
-

Difference Between Fistula and Hemorrhoids
-

Difference Between Omnisexual and Pansexual
-

Difference Between Retinol and Retinyl Palmitate
-

Difference Between Gelatin and Collagen
-

Difference Between Collagen and Keratin
-

Difference Between Pluripotent and Multipotent Stem Cell
-

Difference Between Fistula and Graft
-

Difference Between Seasonal Affective Disorder vs. Depression
-

Difference Between Hashimoto’s and Lupus
-

Difference Between Landslide and Mudslide
-

Difference Between Dielectric Constant and Frequency
-

Difference Between Chipmunk and Gopher
-

Difference Between Aboriginal Skull and Caucasian Skull
-

Difference Between Absolute Threshold and Difference Threshold
-

Difference Between Acetone and Xylene
-

Difference Between Primary and Secondary Hypertension
